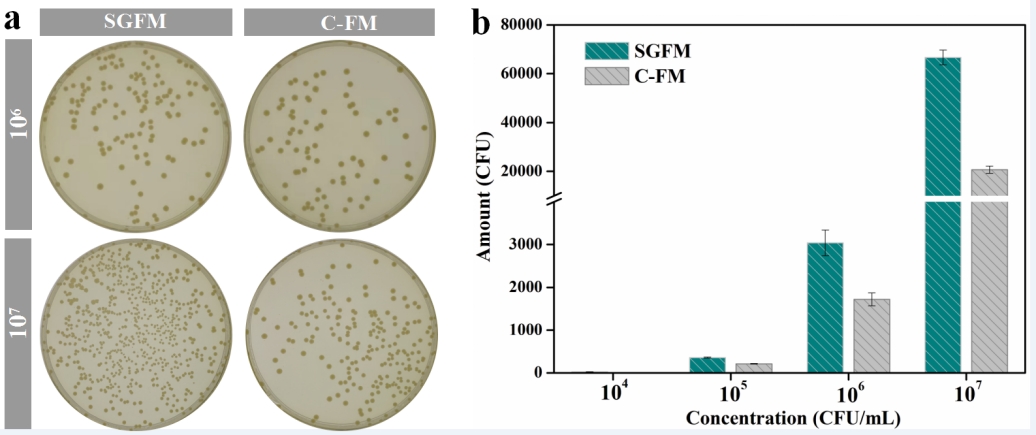

新聞網訊 面對嚴峻的血液制品微生物污染安全挑戰�,我校腫瘤精準醫學研究院、醫工研協同創新中心邢東明教授團隊與青島海爾生物醫療聯手研發微生物快速采集及檢測一體化技術����,獲得山東省重點研發計劃立項支持��。近日,兩項關鍵研究取得重要進展��,研究成果分別在國際權威學術期刊《Journal of Hazardous Materials》和《Journal of Colloid and Interface Science》發表��。

眾所周知���,血液制品安全是關乎千家萬戶的大事���。因此,法規要求必須定時對血液及生物制品的儲存環境進行微生物污染檢測。目前經典的微生物檢測方法是自然沉降法�����,這種檢測方式存在兩方面問題:一是存在“風險盲區”,至少需要培養48小時才可明確結果�,這段時間窗口成為風險盲區��;第二是“測不準”,計算菌落很難準確反應微生物污染源的實際情況�����。上述問題對血液制品污染的及時發現及處置帶來重要隱患����。
那么,能否建立“又快又好又準”的微生物污染檢測方法����?為此�,研究團隊親臨血液制品儲存一線調研情況����、分析問題,和中國血液制品儲存行業的頭部企業海爾生物建立了聯合研發�,創造性提出微生物“綠色過濾+微型采樣+快速定量檢測”的新技術策略����,并建立三大關鍵技術�。
首先,要解決如何讓捕獲的微生物“活的好���、活得長”,以確保檢測的準確性��、靈敏度��。研究團隊通過原料���、工藝的“雙綠色”篩選研究,成功創制出微生物的“綠色抓手”生物膜,能夠實現捕獲的微生物數量和質量雙重保障�����。與業內標桿德國賽多利斯生物膜進行的對標研究顯示�,微生物存活率提升了1.5倍。


其次�����,還要解決如何提高微生物采集的截留率�����,減少“漏網之魚”����。研究團隊通過工藝探索�,通過相分離技術研發了具有蜂窩狀的交聯互通網絡結構膜材料,透氣性好,結構穩定性高,微生物捕獲量是商業化凝膠過濾膜的3.2倍,解決了高效率采集的關鍵技術難題�。

再次��,解決了微生物快速定量檢測的多個環節技術難題。研究團隊通過探索解決了生物膜快速溶、高效洗脫�、提取技術���,實現了微生物樣品最大限度的轉移����、收集能力����。同時探索了相適應的ATP生物發光法,最終實現了捕獲微生物的快速定量檢測,檢測時間縮短到傳統方式的1/288�����。

與業內標桿德國賽多利斯的相關技術及產品對標研究顯示����,研究團隊的研究在空氣微生物捕獲量��、存活率���、快速定量檢測等方面具有明顯優勢����,因此具有很好的產業化前景。目前,項目已完成原理性產品研究并申報多項專利,并獲得山東省重點研發計劃立項支持�。邢東明教授團隊與海爾生物醫療股份公司正在推動產品工業化技術研究��,加快原創成果提能產業、服務社會。

青島大學及附屬醫院為論文的第一單位���,青島海爾生物醫療股份有限公司為第二單位,青島大學腫瘤精準醫學研究院燕賽賽博士和研究生柳青為論文共同第一作者,團隊成員包括劉占杰、劉潤東、高文升、賈秋志、柳欣林��、閆銘喆���、邢琨悅��、郭晗��、姜文豪、馬欣玥、許君琳和張新怡�����,通訊作者為邢東明教授�。該研究得到青島市科技創新高層次人才團隊、山東省重點研發計劃和國家自然科學基金項目的資助與支持。
項目相關研究論文鏈接:
https://doi.org/10.1016/j.jhazmat.2024.134740
https://doi.org/10.1016/j.jcis.2024.05.105
https://doi.org/10.1016/j.talanta.2024.126025






![]() 魯公網安備 37021202000856號
魯公網安備 37021202000856號 ![]()